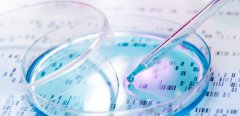
试管保险 | 我选择了做三代试管，还需要买保险吗？

试管科普

-
 高龄试管想成功,还是靠自己!
高龄试管想成功,还是靠自己!试管是一种不孕不育患者常用的治疗方式。但是随着女性年龄的增长,其卵巢功能会逐渐下降,这就意味着需要进行更多的努力来培养卵黄囊。那么高龄试管怎么培养卵黄囊呢? 什么是
作者:木易 99 发布时间:2026-05-11 -
 一文读懂试管:“冻胚”、“冻卵”、“冻精”的区别与联系!
一文读懂试管:“冻胚”、“冻卵”、“冻精”的区别与联系!冻胚”、“冻卵”与“冻精”在试管技术中各司其职,共同为不孕不育患者和希望保留生育力的人群提供了宝贵的支持与帮助。通过了解它们的区别,我们可以更好地理解和利用这些技术
作者:多米 68 发布时间:2026-05-11 -
 高龄也能圆好孕梦:试管成功案例启示录,备孕必看!
高龄也能圆好孕梦:试管成功案例启示录,备孕必看!在追求生育的道路上,高龄夫妇常常面临诸多挑战,但并非不可逾越。通过试管技术,许多高龄夫妇已经成功实现了他们的好孕梦想。以下是对这些成功案例的总结,希望能为正在备孕的
作者:多米 100 发布时间:2026-05-11 -
 揭秘马来西亚试管黑幕:四大骗术横行,如何识破并避免?
揭秘马来西亚试管黑幕:四大骗术横行,如何识破并避免?在马来西亚,试管技术已成为了众多不孕夫妇的最后的希望。然而,随着需求的日益增长,这股希望之光也吸引了不法之徒,企图借此实施欺诈行为。鉴于此,我们整理了一系列内容,为
作者:雨诗 78 发布时间:2026-05-11 -
 首次试管之旅:全面检查项目,为宝宝健康启航保驾护航!
首次试管之旅:全面检查项目,为宝宝健康启航保驾护航!第一次做试管,为了确保母婴双方的健康及提高试管的成功率,需要进行一系列全面而细致的检查项目。这些检查项目旨在为宝宝健康护航。 精子质量检查 在进行试管前,男性也
作者:多米 96 发布时间:2026-05-11 -
 收藏!做试管如何挑选合适的医院
收藏!做试管如何挑选合适的医院试管技术是一种较为先进的助孕方式,对于不孕不育症患者来说是一种福音,但是选择一家合适的医院进行试管操作也非常重要。那么试管选择医院应考虑的主要因素是什么呢? 医院的信誉
作者:木易 64 发布时间:2026-05-11 -
 揭秘试管多胎减胎潜在风险,四点关键信息需掌握!
揭秘试管多胎减胎潜在风险,四点关键信息需掌握!试管多胎减胎手术,不仅是对现代医学技术精挑战,更是触及伦理边界与生命价值深层意义的考量。在踏上这一决策之路前,我们必须全面而审慎地评估手术潜在的风险,包括其对孕妇心
作者:雨诗 175 发布时间:2026-05-11 -
 试管之旅:如何精心挑选一位合适的医生
试管之旅:如何精心挑选一位合适的医生试管技术是一项高科技的医学手段,对于很多不孕不育患者来说,是实现生育愿望的唯一途径。在进行试管治疗前,需要找到一位专业的医生进行咨询。那么做试管如何咨询医生
作者:木易 145 发布时间:2026-05-11 -
 窦性心律不齐是心脏病吗?试管要不要治疗?一文告诉你答案
窦性心律不齐是心脏病吗?试管要不要治疗?一文告诉你答案试管技术是现代医学的重要成果,但是对于患有窦性心律不齐的夫妇来说,他们是否适合进行试管技术呢?本文将为您详细。 试管技术是一种辅助生育技术,可以帮助无法自然受孕
作者:木易 103 发布时间:2026-05-11 -
 请查收这份试管套餐攻略,帮你省心又省钱
请查收这份试管套餐攻略,帮你省心又省钱在选择试管时,很多人会面临一个问题,是选择套餐还是单独交费用更好呢?本文将详细介绍试管的相关知识,帮助你做出最佳选择。 试管选套餐好还是单交好? 试管是一种现代医
作者:木易 163 发布时间:2026-05-11 -
试管保险 | 我选择了做三代试管,还需要买保险吗?
试管保险 | 我选择了做三代试管,还需要买保险吗?随着科技的发展,三代试管生孩子已经成为一种不断普及的生育方式。但是这样的孩子是否能够购买保险呢?下面我们来详细介绍。 什么是三代试管技术? 三代试管是指通过人类辅助生殖技术中
作者:木易 82 发布时间:2026-05-11 -
 科普|试管更容易生双胞胎吗?
科普|试管更容易生双胞胎吗?随着人们对试管技术认知度的提高,越来越多的夫妇选择通过这种方式拥有自己的孩子。而在试管过程中,很多人会考虑选择双胞胎还是单胎。那么试管双胞胎真的比单胎更容易
作者:木易 187 发布时间:2026-05-11
